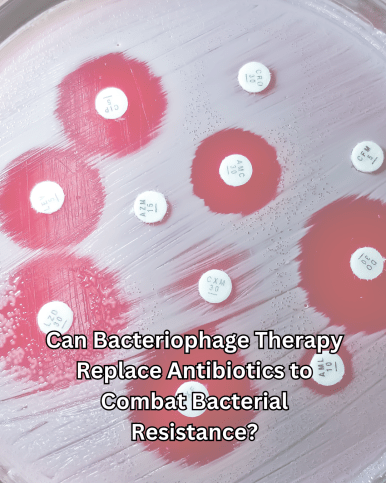
Can Bacteriophage Therapy Replace Antibiotics to Combat Bacterial Resistance?

Key Points
- Research suggests bacteriophages, viruses that kill bacteria, could help combat antibiotic resistance, a growing global health crisis.
- It seems likely that phages won’t fully replace antibiotics but may complement them, especially for multidrug-resistant infections.
- The evidence leans toward phages being effective in specific cases, like chronic infections, with some success stories in countries like Georgia and Poland.
- There’s ongoing debate about regulatory hurdles and the need for more clinical trials to standardize phage therapy.
Antibiotic resistance is a silent pandemic, with bacteria evolving to resist drugs, causing 133,000 direct deaths yearly in the European Region alone, and indirectly linked to 541,000 deaths annually, costing the EU/EEA €11.7 billion yearly in health and productivity losses. 1 This crisis threatens to undo medical progress, making infections like urinary tract infections potentially deadly.
Bacteriophages, or phages, are viruses that infect and destroy bacteria, offering a potential alternative. They’ve been used for over a century in some regions and are gaining attention as antibiotics fail against multidrug-resistant (MDR) bacteria, like those in the ESKAPE group (Enterococcus faecium, Staphylococcus aureus, Klebsiella pneumoniae, etc.).

ESKAPE pathogens are a group of highly drug-resistant bacteria that pose a significant threat to public health due to their ability to “escape” the effects of antibiotics. The term ESKAPE is an acronym for the six bacterial species in this group:
- Enterococcus faecium
- Staphylococcus aureus
- Klebsiella pneumoniae
- Acinetobacter baumannii
- Pseudomonas aeruginosa
- Enterobacter species
Why Are ESKAPE Pathogens Important?
- They are major causes of hospital-acquired infections (HAIs).
- They exhibit high antibiotic resistance, making infections difficult to treat.
- They can cause severe illnesses, such as pneumonia, bloodstream infections, and urinary tract infections.
- Some of them have biofilm-forming abilities, which makes them even harder to eradicate.
Due to their resistance mechanisms, these bacteria are a major focus in antimicrobial stewardship programs, and new antibiotic development efforts aim to combat them.
How Bacteriophages Work
Phages attach to bacteria, inject their genetic material, and replicate inside, eventually bursting the cell to release more phages. With an estimated 10^30-31 phages in the biosphere, they’re highly abundant and specific, targeting only certain bacterial strains without harming human cells. This specificity could reduce side effects compared to broad-spectrum antibiotics.
Phages are the most abundant biological entities on Earth, with an estimated 10^30-31 in the biosphere, outnumbering bacterial cells by a factor of 10 (Principi et al., 2022). They operate by attaching to specific bacterial receptors, injecting their genetic material, and hijacking the bacterial machinery to produce progeny phages, ultimately lysing the cell. This lytic cycle ensures the destruction of the target bacterium, with phages being highly specific to certain strains, reducing the risk of disrupting the human microbiome (Górski et al., 2019).
This specificity contrasts with broad-spectrum antibiotics, which can kill beneficial bacteria and contribute to dysbiosis. Phages also self-replicate within the host, potentially providing a sustained therapeutic effect, and have low toxicity, with few reported side effects in clinical use (Górski et al., 2019).
Pharmacodynamics and Pharmacokinetics
Phage therapy relies on two approaches: active treatment, where low phage concentrations lead to progeny release, and passive treatment, using sufficient concentrations for immediate effect. The multiplicity of infection (MOI) and killing titer guide therapy, with low toxicity and no toxic by-products from immune degradation (Górski et al., 2019).
Pharmacokinetics are influenced by absorption, distribution, metabolism, excretion, decay, and proliferation. Routes include parenteral, oral, topical, and aerosolization, with examples like intraperitoneal injection being most effective in murine burn models for P. aeruginosa and oral dosing with 0.025% CaCO3 protecting phages from stomach acids (Górski et al., 2019).
Advantages Over Antibiotics
Phages offer several advantages, making them a compelling alternative:
- High Specificity: For example, phage P100 infects over 90% of Listeria monocytogenes isolates, allowing precise targeting of pathogens (Górski et al., 2019).
- Efficacy Against MDR Bacteria: Phages can treat infections caused by ESKAPE organisms, which are often resistant to multiple antibiotics (Lin et al., 2017).
- Self-Replication: Phages multiply at the infection site, potentially reducing the need for high initial doses (Górski et al., 2019).
- Low Toxicity: Clinical trials, such as a study on 26 patients receiving 10^9 PFU/kg, showed no antibody response in 8 cases and clearance within 4 days in 18 others, indicating good tolerance (Górski et al., 2019).
- Biofilm Disruption: Phages can penetrate and disrupt bacterial biofilms, a common challenge in chronic infections, with engineered phages enhancing this capability (Lin et al., 2017).
Current Clinical Use and Case Studies
Phage therapy is actively practiced in countries like Russia, Georgia, and Poland, where it has been part of medical practice for decades. The Eliava Phage Therapy Centre in Georgia, for instance, has treated over 8,400 patients since 2018, emphasizing patient-centered, personalized care (World Health Organization, 2024). In Poland, the cure rate is close to 40%, based on historical data (Principi et al., 2022).
Notable case studies include:
- Pim van Vliet: An 84-year-old with a chronic urinary tract infection caused by MDR Klebsiella pneumoniae, unresponsive to antibiotics. Starting phage therapy in May 2017 at the Eliava Institute, he recovered within a month and has remained infection-free, recently celebrating his 91st birthday (World Health Organization, 2024).
- Marit: Suffering from chronic urethral infections due to MDR E. coli from age 3 to 11, Marit received phage therapy at Eliava in 2018. After a 14-day clinic treatment and six months at home, the bacteria were eradicated. Now 18, she is healthy, studying, and playing sports (World Health Organization, 2024).
Clinical trials also show promise: for example, a trial for burns treated 27 patients with a phage cocktail (10^6 PFU/mL), achieving a median endpoint of 144 hours compared to 47 hours with standard care (Górski et al., 2019). However, formal trials are limited, and access to Russian and Polish journals can be a barrier.
Challenges and Limitations
Despite the promise, several challenges persist:
- Immune Response: Phages can trigger innate and adaptive immune responses, with variable antibody induction. High doses (10^9 PFU/mL) in mice showed increased IgG after 3–5 weeks and IgA after 63–79 days, while human trials showed no response in 8 of 26 patients and clearance within 4 days in 18 others (Górski et al., 2019). Low-dose regimes can mitigate neutralizing antibodies.
- Bacterial Resistance to Phages: Up to 80% resistance in intestinal studies and 50% in sepsis models, mitigated by phage cocktails, genetic engineering, and exploiting fitness costs of resistant mutants (Górski et al., 2019).
- Regulatory Hurdles: Phages lack specific classification, complicating trials and commercialization. Belgium defined them as medicinal/industrial products in 2016, and compassionate use is permitted under programs like the US FDA Expanded Access Program (Górski et al., 2019).
- Standardization Needs: No standardized protocols for administration, dosing, or phage selection, with current collections like Finland’s ca. 600 phages estimated to need 1500–2000 to cover 70–80% of MDR isolates (Principi et al., 2022).
- Access Barriers: Limited access to Eastern European journals and lack of integration into medical curricula hinder adoption (World Health Organization, 2024).
Future Prospects and Global Efforts
The future of phage therapy lies in combination with antibiotics, leveraging phage-antibiotic synergy, where antibiotics induce phage production by bacterial hosts (Kortright et al., 2022). Genetic engineering expands host ranges, with examples like T2 phage modified to infect E. coli O157:H7, and adds functionalities like CRISPR-Cas for sequence-specific antimicrobials (Górski et al., 2019).
The WHO is leading efforts to build evidence, with the Roadmap on AMR (2023–2030) targeting safer environments by 2030 (World Health Organization, 2024). This includes webinars, expert dialogues, and regulatory discussions from a One Health perspective, emphasizing human, animal, and environmental health. Educational needs, as highlighted by patients’ families like Lies (Pim’s daughter), call for health worker training and legislation to support early-stage use, preventing chronic suffering (World Health Organization, 2024).
Conclusion
Bacteriophages offer a promising, though not complete, replacement for antibiotics, particularly for MDR infections. While success stories like Pim and Marit illustrate potential, challenges like regulatory barriers and immune responses require resolution (World Health Organization, 2024). With global efforts and research, phage therapy could become a cornerstone of future medicine, addressing the silent pandemic of bacterial resistance.
Did you find this interesting? Leave a comment below.
References
- Górski, A., Międzybrodzki, R., & Jończyk-Matysiak, E. (2019). Bacteriophages as alternatives to antibiotics in clinical care. Antibiotics, 8(4), 179. https://doi.org/10.3390/antibiotics8040179
- Kortright, K. E., Chan, B. K., & Turner, P. E. (2022). Bacteriophage and bacterial susceptibility, resistance, and tolerance to antibiotics. Pharmaceuticals, 15(7), 867. https://doi.org/10.3390/ph15070867
- Lin, D. M., Koskella, B., & Lin, H. C. (2017). Advantages and limitations of bacteriophages for the treatment of bacterial infections. Frontiers in Pharmacology, 8, 513. https://doi.org/10.3389/fphar.2019.00513
- Principi, N., Silvestri, E., & Esposito, S. (2022). Can bacteriophages replace antibiotics? Antibiotics, 11(6), 768. https://doi.org/10.3390/antibiotics11060768
- World Health Organization. (2024, June 25). Building evidence for the use of bacteriophages against antimicrobial resistance. https://www.who.int/europe/news/item/25-06-2024-building-evidence-for-the-use-of-bacteriophages-against-antimicrobial-resistance
- World Health Organization. (n.d.). Bacteriophages and their use in combating antimicrobial resistance. https://www.who.int/europe/news-room/fact-sheets/item/bacteriophages-and-their-use-in-combating-antimicrobial-resistance